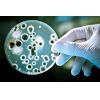

Un team internazionale di 32 esperti della Cystic Fibrosis Foundation ha stilato le nuove linee guida per la diagnosi della fibrosi cistica. Gli esperti sono arrivati da 9 paesi e si sono occupati della revisione della letteratura...
Leggi tutto...Aggiornate le linee guida per la diagnosi della fibrosi cistica